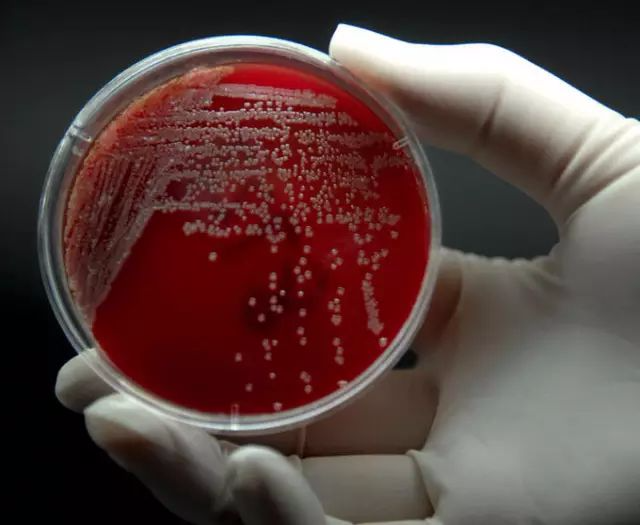
图片
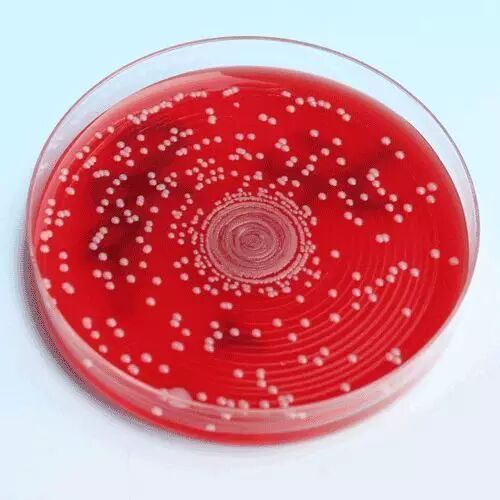
图片

几种常见的微生物接种方法优缺点比较!
一、划线法:
此法主要用于菌种分纯,获得单菌落.
由接种环沾取少许待分离的材料,在无菌平板表面进行平行划线、扇形划线或其他形式的连续划线,微生物细胞数量将随着划线次数的增加而减少,并逐步分散开来,如果划线适宜的话,微生物能一一分散,经培养后,可在平板表面得到单菌落。
优点:可以观察菌落特征,对混合菌进行分离。
缺点:不能用于菌落计数。
二、涂布法:
此法主要用于菌落总数计数.
先将培养基熔化后趁热倒入无菌平板中,然后用无菌吸管吸取0.1ml 菌液接种在已凝固的琼脂平板上。再用无菌L 型玻璃棒将菌液在平板上涂抹均匀,将涂抹好的平板平放于桌上20~30min,使菌液渗透入培养基内,然后将平板倒转,保温培养,至长出菌落后即可计数。
优点:可以计数,可以观察菌落特征。
缺点:接种前需梯度稀释,吸收量较少,较麻烦,平板不干燥效果不好,容易蔓延。

三、倾倒法:
此法主要用于菌落总数的计数.
吸取1ml 菌液加入平板中,倒入已融化并冷却至45~50℃的细菌培养基,轻轻转动平板,使菌液与培养基混合均匀,冷疑后倒置,适温培养。至长出菌落后即可计数。
优点:可以计数,较方便。
缺点:接种前需梯度稀释,不能观察菌落特征,不适用于严格好氧菌和热敏感菌。

四、斜面接种法:
此法主要用于保存菌种,或观察细菌的某些生化特性和动力.
用接种环或接种针伸入菌种管内,挑取用来移种的菌落。伸入斜面培养管内,先从斜面底部到顶端拖一条接种线,再自下而上蜿蜒划线,或直接自下而上地蜿蜒划线。接种完成之后,用火焰灭菌培养管口,并塞上棉塞,置于37℃培养。

五、液体培养基接种法:
此法主要用于菌液比浊实验
用灭菌接种环挑取菌落或标本,在试管内壁与液面交界处轻轻研磨,使细菌均匀得散落在液体培养基中。

六、螺旋接种法:
此法主要用于菌落总数计数
可以在无任何全部或中间稀释的情况下快速细菌接种。对数减少的样品容量以阿基米德螺旋线的形式被自动分注在旋转式培养基表面。培养基上每一点的容量可以被知晓和校准。菌液的浓度可以通过培养皿上一定区域的菌落数量除以同区域样品分注量来计算。
优点:螺旋接种法菌液无需稀释(其他接种方法均需经过梯度稀释才能计菌落数),自动化接种,效率高,可节省3/4 的耗材和时间。
缺点:产品成本高,适用于样品量比较大的实验。
网络
展源
何发
热点文章
-
硫酸稀释是酸入水还是水入酸?
2026-04-23
-
【收藏】标准溶液的配制和计算
2026-04-07
-
【必看】实验滴定终点变色顺口溜
2026-03-24
-
【必看】红外光谱仪结构图与原理
2026-04-28
-
提效增能·创新提质 色谱质谱助力食品安全技术能力建设
2026-03-24
-
【收藏】常用溶液配制速查
2026-04-10
-
【标准】4月即将实施
2026-03-31
-
独立百天,新生启航:Solstice Advanced Materials中国首秀,锚定先进计算、可持续发展、生命科学新航道
2026年1月末,距离从霍尼韦尔正式分拆独立,并在纳斯达克挂牌上市将满百日时,全新的特种材料公司 Solstice Advanced Materials在上海举办了其独立运营后的首次中国媒体见面会。
作者:张明
-
安捷伦在中国:加速本土创新与绿色发展的双重推进
-
洞察未来,共谋发展 “ 数·智·未来 ” 安捷伦未来实验室媒体圆桌会成功举办
-
食品检验理化常用国家标准与要点
-
水分测定方法开发研究&检测相关问题故障分析解决解读
-
药物常用的晶型表征方法









评论
加载更多